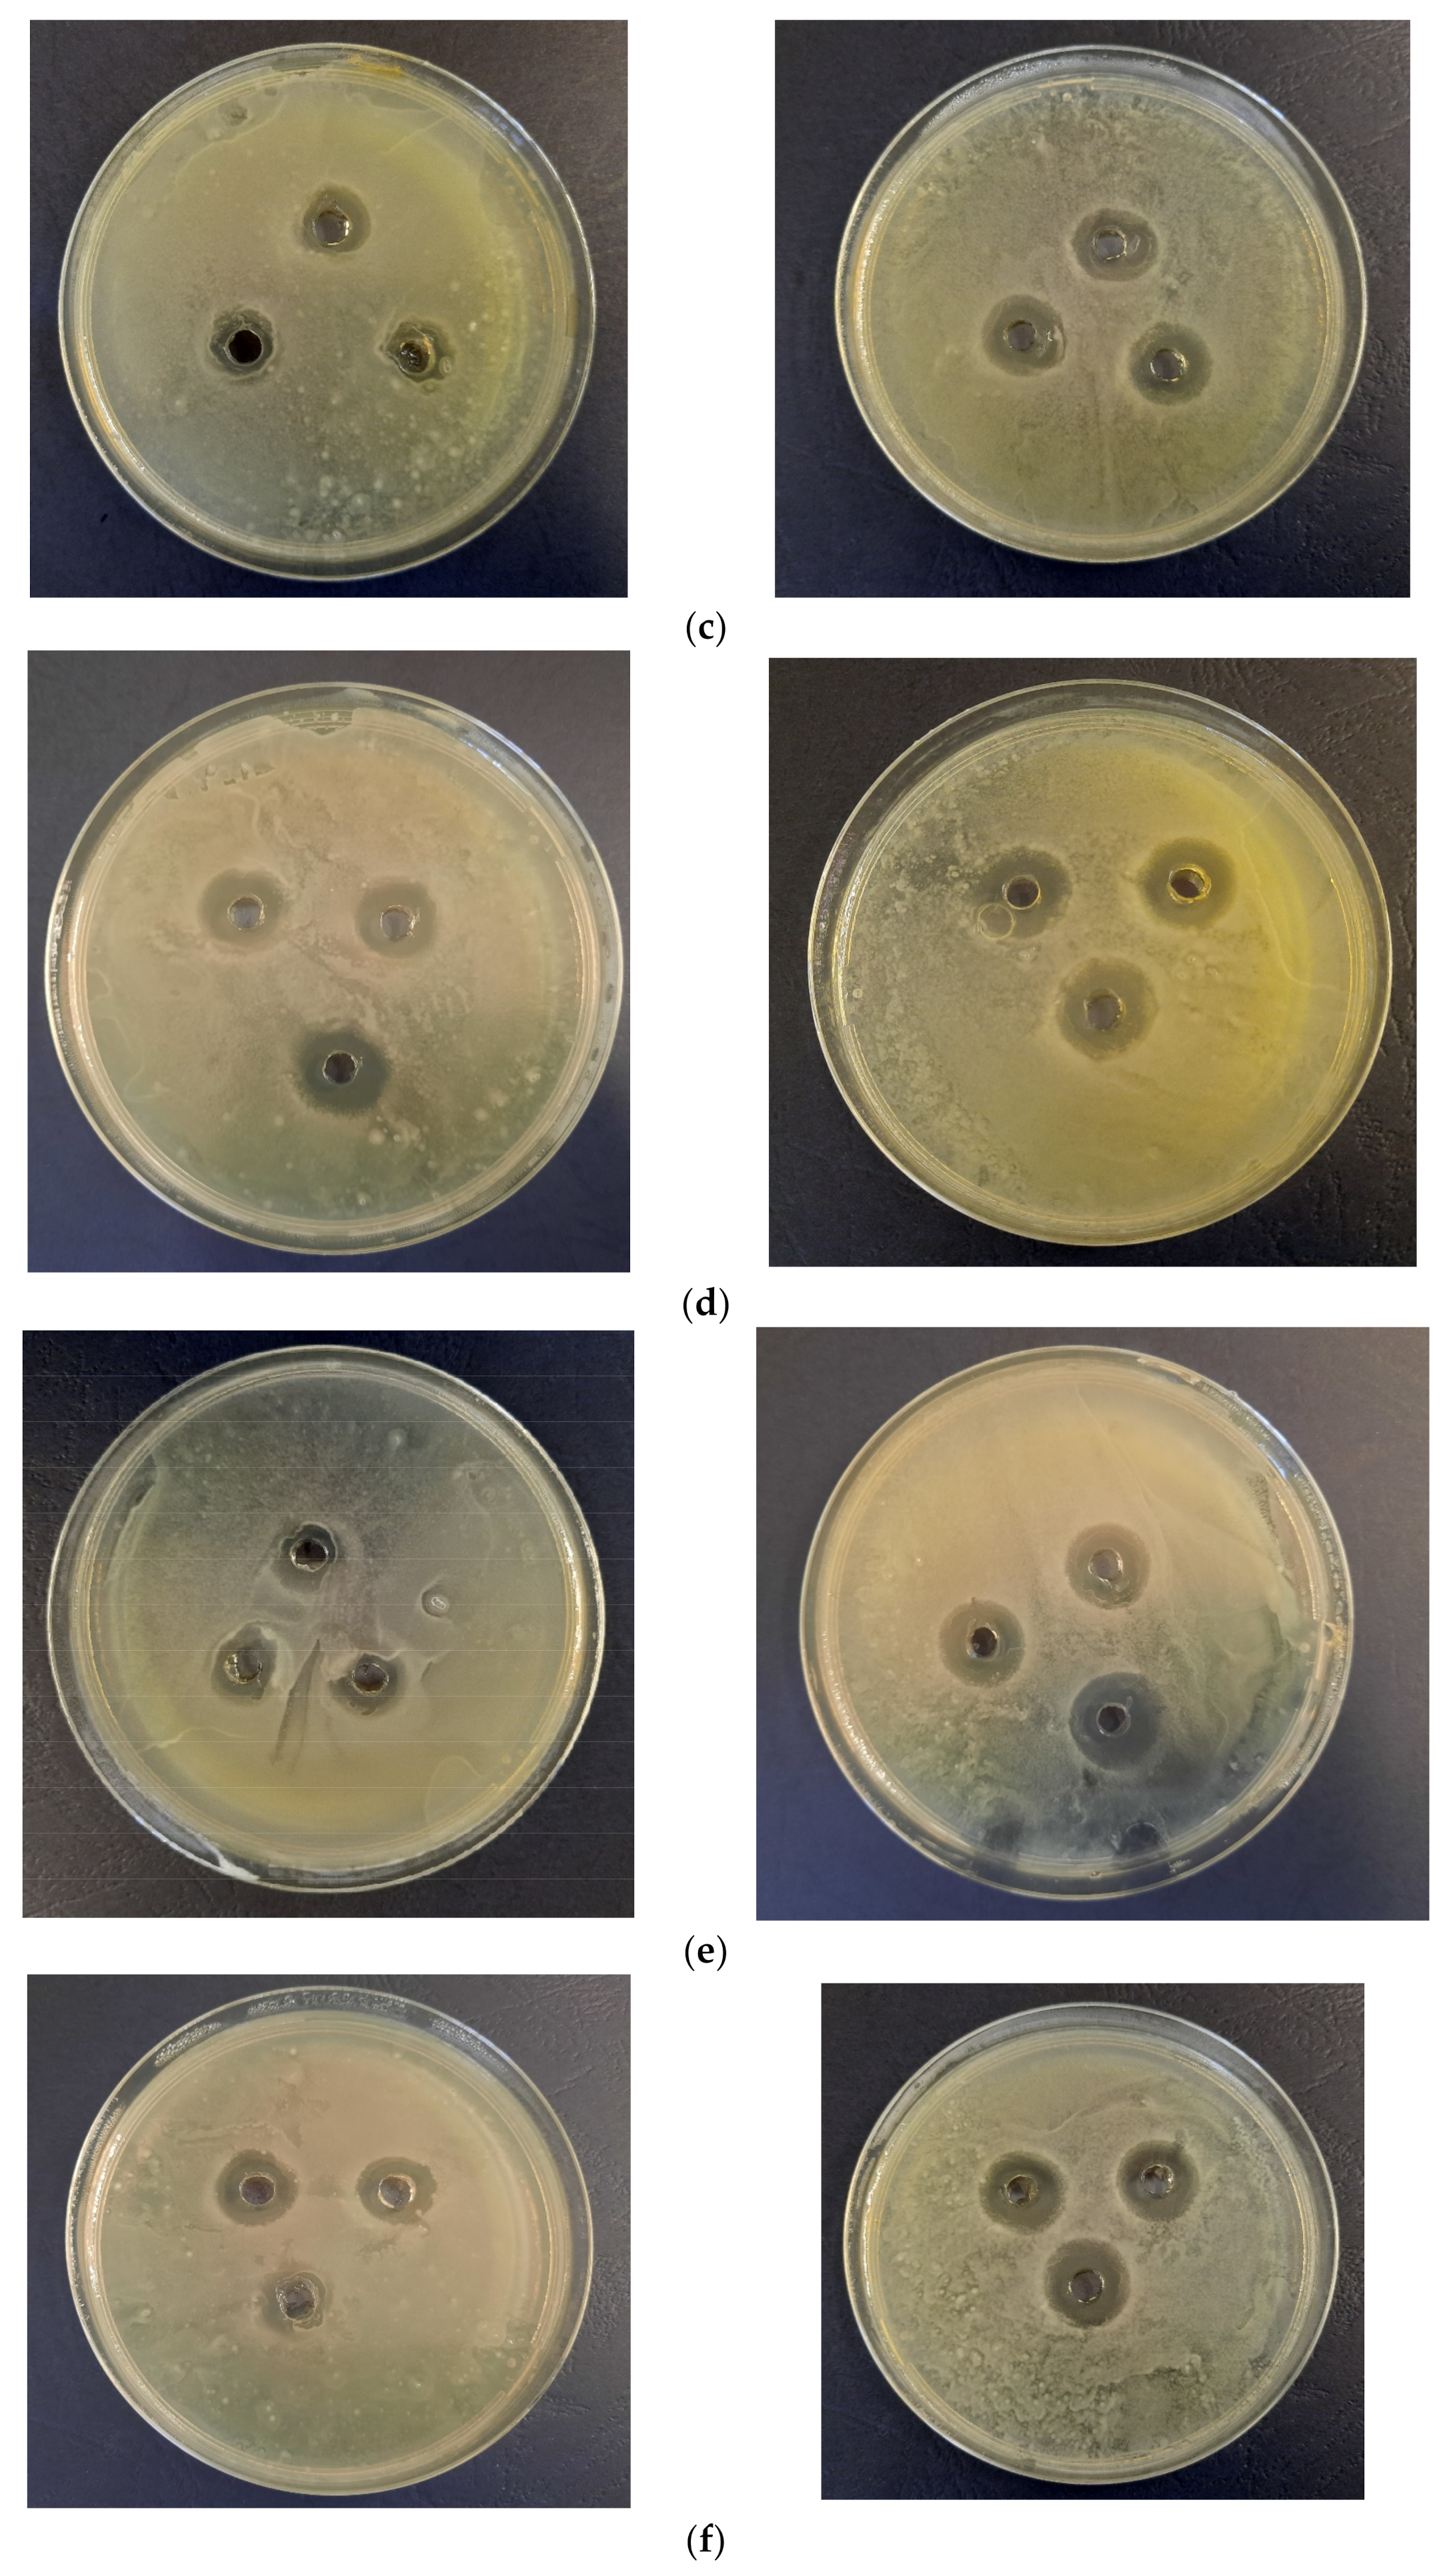
Materials 16 03472 g010b Materials 16 03472 g010b

Phytosynthesis of Silver Nanoparticles Using Leonurus cardiaca L. Extracts
Abstract
1. Introduction
2. Materials and Methods
2.1. Vegetal Material
2.2. Obtaining of Natural Extracts
2.3. Characterisation of Natural Extracts
2.4. Phytosynthesis and Characterization of Silver Nanoparticles
- -
- UV-Vis spectrometry, for the evaluation of the phytosynthesis process (as AgNP usually exhibit an absorption maximum in the 400–550 nm region), to estimate the NPs dimensions, and to evaluate the stability of the NPs solutions (by recording the UV-Vis spectra of the NPs solution after 9 months from the synthesis) [38]. For the determinations, a Rigol Ultra 3660 UV-Vis spectrometer (Rigol Technologies Inc., Beijing, China, optical resolution 0.5 nm) was used, the analyses being performed in the range 375–550 nm.
- -
- Dynamic light scattering (DLS), for the determination of the NPs’ hydrodynamic diameter [40]; for DLS analysis, five/ten determinations were performed for each sample, using a Zetasizer Nano ZS ZEN 3600 instrument (Malvern Instruments, Malvern, UK) capable of determining particle size in the range 0.6–6000 nm.
- -
- X-ray diffraction (XRD), for the determination of the crystallin structure and crystallite size [41], using a 9 kW Rigaku SmartLab diffractometer (Rigaku Corp., Tokyo, Japan), under the following operating parameters: 45 kV, 200 mA, CuKα radiation (1.54059 Å), 2θ/θ scanning mode; the diffractograms were recorded between 7 and 90° (2θ). Components were identified by comparison with ICDD data (ICDD, Newtown Square, PA, USA), using the equipment’s software (PDXL, v. 2.7.2.0, Rigaku Corp., Tokyo, Japan), while the crystallite size was determined using the Debye–Scherrer Equation (1):where Dp = the average size of the crystallites, K—the Scherrer constant (K = 0.94), β = the width at half-height of the diffraction maximum, θ = the Bragg angle, λ = the wavelength—1.54059 Å).
- -
- Transmission Electron Microscopy (TEM) for the visualization of selected NPs, using a Tecnai G2 F20 TWIN Cryo-TEM equipment (FEI Company, OR, USA), at an accelerating voltage of 300 kV and a resolution of 1 Å. The microscope was equipped with an energy dispersive X-ray spectroscopy (EDX) accessory (Oxford Instruments, Abingdon, UK), allowing the evaluation of the elemental composition of the samples.
2.5. Evaluation of Biological Properties
2.6. Statistical Analysis and Data Representation
3. Results
3.1. Extracts Compositional Evaluation
3.2. Analythical Characterization of the NPs
3.3. Biological Properties Evaluation
4. Conclusions
Author Contributions
Funding
Institutional Review Board Statement
Informed Consent Statement
Data Availability Statement
Acknowledgments
Conflicts of Interest
References
- Paiva-Santos, A.C.; Herdade, A.M.; Guerra, C.; Peixoto, D.; Pereira-Silva, M.; Zeinali, M.; Mascarenhas-Melo, F.; Paranhos, A.; Veiga, F. Plant-mediated green synthesis of metal-based nanoparticles for dermopharmaceutical and cosmetic applications. Int. J. Pharm. 2021, 597, 120311. [Google Scholar] [CrossRef] [PubMed]
- Saha, J.; Begum, A.; Mukherjee, A.; Kumar, S. A novel green synthesis of silver nanoparticles and their catalytic action in reduction of Methylene Blue dye. Sustain. Environ. Res. 2017, 27, 245–250. [Google Scholar] [CrossRef]
- Ungureanu, C.; Tihan, G.T.; Zgârian, R.G.; Fierascu, I.; Baroi, A.M.; Răileanu, S.; Fierăscu, R.C. Metallic and Metal Oxides Nanoparticles for Sensing Food Pathogens—An Overview of Recent Findings and Future Prospects. Materials 2022, 15, 5374. [Google Scholar] [CrossRef] [PubMed]
- Baroi, A.M.; Sieniawska, E.; Świątek, Ł.; Fierascu, I. Grape Waste Materials—An Attractive Source for Developing Nanomaterials with Versatile Applications. Nanomaterials 2023, 13, 836. [Google Scholar] [CrossRef]
- Korde, P.; Ghotekar, S.; Pagar, T.; Pansambal, S.; Oza, R.; Mane, D. Plant extract assisted eco-benevolent synthesis of selenium nanoparticles-a review on plant parts involved, characterization and their recent applications. J. Chem. Rev. 2020, 2, 157–168. [Google Scholar]
- Ramteke, C.; Chakrabarti, T.; Sarangi, B.K.; Pandey, R.-A. Synthesis of Silver Nanoparticles from the Aqueous Extract of Leaves of Ocimum sanctum for Enhanced Antibacterial Activity. J. Chem. 2013, 2013, 278925. [Google Scholar] [CrossRef]
- Simonetti, G.; Palocci, C.; Valletta, A.; Kolesova, O.; Chronopoulou, L.; Donati, L.; Di Nitto, A.; Brasili, E.; Tomai, P.; Gentili, A.; et al. Anti-Candida Biofilm Activity of Pterostilbene or Crude Extract from Non-Fermented Grape Pomace Entrapped in Biopolymeric Nanoparticles. Molecules 2019, 24, 2070. [Google Scholar] [CrossRef]
- Heydari, M.; Ghoreishi, S.M.; Khoobi, A. Novel electrochemical procedure for sensitive determination of Sudan II based on nanostructured modified electrode and multivariate optimization. Measurement 2019, 142, 105–112. [Google Scholar] [CrossRef]
- Roy, A.; Sharma, A.; Yadav, S.; Jule, L.T.; Krishnaraj, R. Nanomaterials for Remediation of Environmental Pollutants. Bioinorg. Chem. Appl. 2021, 2021, 1764647. [Google Scholar] [CrossRef]
- Ahmad, M.M.; Mushtaq, S.; Al Qahtani, H.S.; Sedky, A.; Alam, M.W. Investigation of TiO2 Nanoparticles Synthesized by Sol-Gel Method for Effectual Photodegradation, Oxidation and Reduction Reaction. Crystals 2021, 11, 1456. [Google Scholar] [CrossRef]
- Malik, A.; Khan, J.M.; Alhomida, A.S.; Ola, M.S.; Alshehri, M.A.; Ahmad, A. Metal nanoparticles: Biomedical applications and their molecular mechanisms of toxicity. Chem. Pap. 2022, 76, 6073–6095. [Google Scholar] [CrossRef]
- Gupta, R.; Xie, H. Nanoparticles in Daily Life: Applications, Toxicity and Regulations. J. Environ. Pathol. Toxicol. Oncol. 2018, 37, 209–230. [Google Scholar] [CrossRef] [PubMed]
- Husain, S.; Nandi, A.; Simnani, F.Z.; Saha, U.; Ghosh, A.; Sinha, A.; Sahay, A.; Samal, S.K.; Panda, P.K.; Verma, S.K. Emerging Trends in Advanced Translational Applications of Silver Nanoparticles: A Progressing Dawn of Nanotechnology. J. Funct. Biomater. 2023, 14, 47. [Google Scholar] [CrossRef] [PubMed]
- Fierascu, I.; Fierascu, I.C.; Brazdis, R.I.; Baroi, A.M.; Fistos, T.; Fierascu, R.C. Phytosynthesized Metallic Nanoparticles—Between Nanomedicine and Toxicology. A Brief Review of 2019′s Findings. Materials 2020, 13, 574. [Google Scholar] [CrossRef]
- Fierascu, R.C.; Fierascu, I.; Lungulescu, E.M.; Nicula, N.; Somoghi, R.; Diţu, L.M.; Ungureanu, C.; Sutan, A.N.; Drăghiceanu, O.A.; Paunescu, A.; et al. Phytosynthesis and radiation-assisted methods for obtaining metal nanoparticles. J. Mater. Sci. 2020, 55, 1915–1932. [Google Scholar] [CrossRef]
- Iravani, S.; Korbekandi, H.; Zolfaghari, B. Phytosynthesis of Nanoparticles. In Nanotechnology and Plant Sciences; Siddiqui, M., Al-Whaibi, M., Mohammad, F., Eds.; Springer: Cham, Switzerland, 2015; pp. 203–258. [Google Scholar]
- Bordiwala, R.V. Green synthesis and Applications of Metal Nanoparticles—A Review Article. Results Chem. 2023, 5, 100832. [Google Scholar] [CrossRef]
- Maťátková, O.; Michailidu, J.; Miškovská, A.; Kolouchová, I.; Masák, J.; Čejková, A. Antimicrobial properties and applications of metal nanoparticles biosynthesized by green methods. Biotechnol. Adv. 2022, 58, 107905. [Google Scholar] [CrossRef]
- Alam, M.W.; Aamir, M.; Farhan, M.; Albuhulayqah, M.; Ahmad, M.M.; Ravikumar, C.R.; Dileep Kumar, V.G.; Ananda Murthy, H.C. Green Synthesis of Ni-Cu-Zn Based Nanosized Metal Oxides for Photocatalytic and Sensor Applications. Crystals 2021, 11, 1467. [Google Scholar] [CrossRef]
- Khalil, R.; Kelany, N.A.; Ibrahim, M.A.; Al-Senani, G.M.; Mostafa, A.M. Linear and Nonlinear Optical Properties of PVA:SA Blend Reinforced by TiO2 Nanoparticles Prepared by Flower Extract of Aloe Vera for Optoelectronic Applications. Coatings 2023, 13, 699. [Google Scholar] [CrossRef]
- Ansari, M.; Ahmed, S.; Abbasi, A.; Hamad, N.A.; Ali, H.M.; Khan, M.T.; Haq, I.U.; Zaman, Q.u. Green Synthesized Silver Nanoparticles: A Novel Approach for the Enhanced Growth and Yield of Tomato against Early Blight Disease. Microorganisms 2023, 11, 886. [Google Scholar] [CrossRef] [PubMed]
- Vizitiu, D.E.; Sardarescu, D.I.; Fierascu, I.; Fierascu, R.C.; Soare, L.C.; Ungureanu, C.; Buciumeanu, E.C.; Guta, I.C.; Pandelea, L.M. Grapevine Plants Management Using Natural Extracts and Phytosynthesized Silver Nanoparticles. Materials 2022, 15, 8188. [Google Scholar] [CrossRef]
- Bojor, O. Guide of Medicinal and Aromatic Plants from A to Z; Fiat Lux: Bucharest, Romania, 2003; pp. 94–95. [Google Scholar]
- Shikov, A.N.; Pozharitskaya, O.N.; Makarov, V.G.; Wagner, H.; Verpoorte, R.; Heinrich, M. Medicinal plants of the Russian pharmacopoeia; their history and applications. J. Ethnopharmacol. 2014, 154, 481–536. [Google Scholar] [CrossRef] [PubMed]
- Zhang, R.H.; Liu, Z.K.; Yang, D.S.; Zhang, X.J.; Sun, H.D.; Xiao, W.L. Phytochemistry and pharmacology of the genus Leonurus: The herb to benefit the mothers and more. Phytochemistry 2018, 147, 167–183. [Google Scholar] [CrossRef] [PubMed]
- Ritter, M.; Melichar, K.; Strahler, S.; Kuchta, K.; Schulte, J.; Sartiani, L.; Cerbai, E.; Mugelli, A.; Mohr, F.W.; Rauwald, H.W.; et al. Cardiac and electrophysiological effects of primary and refined extracts from Leonurus cardiaca L. (Ph.Eur.). Planta. Medica. 2010, 76, 572–582. [Google Scholar] [CrossRef] [PubMed]
- Sadowska, B.; Micota, B.; Rozalski, M.; Redzynia, M.; Rozalski, M. The immunomodulatory potential of Leonurus cardiaca extract in relation to endothelial cells and platelets. J. Innate Immun. 2017, 23, 285–295. [Google Scholar] [CrossRef]
- Micota, B.; Sadowska, B.; Podsȩdek, A.; Paszkiewicz, M.; Sosnowska, D.; Różalska, B. Is it true that plant-derived polyphenols are always beneficial for the human? In vitro study on Leonurus cardiaca extract properties in the context of the pathogenesis of Staphylococcus aureus infections. J. Med. Microbiol. 2016, 65, 1171–1181. [Google Scholar] [CrossRef]
- Krishnaiah, D.; Sarbatly, R.; Nithyanandam, R. A review of the antioxidant potential of medicinal plant species. Food Bioprod. Process. 2011, 89, 217–233. [Google Scholar] [CrossRef]
- European Medicines Agency. Assessment Report on Leonurus cardiaca L., Herba. Available online: https://www.ema.europa.eu/documents/herbal-report/final-assessment-report-leonurus-cardiaca-l-herba_en.pdf (accessed on 26 March 2023).
- Rusch, C.; Hennig, L.; Rauwald, H. 7-Chloro-6-desoxy-harpagide, a major iridoid glucoside from Leonurus cardiaca L. (Ph. Eur.). Planta Med. 2010, 76, P235. [Google Scholar] [CrossRef]
- Kuchta, K.; Volk, R.B.; Rauwald, H.W. Stachydrine in Leonurus cardiaca, Leonurus japonicus, Leonotis leonurus: Detection and quantification by instrumental HPTLC and 1H-qNMR analyses. Die Pharm. 2013, 68, 534–540. [Google Scholar]
- Kuchta, K.; Ortwein, J.; Hennig, L.; Rauwald, H.W. 1H-qNMR for direct quantification of stachydrine in Leonurus japonicus and L. cardiaca. Fitoterapia 2014, 96, 8–17. [Google Scholar] [CrossRef]
- Azimova, S.S.; Glushenkova, A.I. Leonurus cardiaca L. In Lipids, Lipophilic Components and Essential Oils from Plant Sources; Azimova, S.S., Glushenkova, A.I., Vinogradova, V.I., Eds.; Springer: London, UK, 2012; pp. 425–426. [Google Scholar]
- Im, A.R.; Han, L.; Kim, E.R.; Kim, J.; Kim, Y.S.; Park, Y. Enhanced antibacterial activities of leonuri herba extracts containing silver nanoparticles. Phytother. Res. 2012, 26, 1249–1255. [Google Scholar] [CrossRef] [PubMed]
- Fierascu, R.C.; Fierascu, I.; Ortan, A.; Fierascu, I.C.; Anuta, V.; Velescu, B.S.; Pituru, S.M.; Dinu-Pirvu, C.E. Leonurus cardiaca L. as a Source of Bioactive Compounds: An Update of the European Medicines Agency Assessment Report (2010). Biomed. Res. Int. 2019, 2019, 4303215. [Google Scholar] [CrossRef]
- Fierascu, R.C.; Georgiev, M.I.; Fierascu, I.; Ungureanu, C.; Avramescu, S.M.; Ortan, A.; Georgescu, M.I.; Sutan, A.N.; Zanfirescu, A.; Dinu-Pirvu, C.E.; et al. Mitodepressive, antioxidant, antifungal and anti-inflammatory effects of wild-growing Romanian native Arctium lappa L. (Asteraceae) and Veronica persica Poiret (Plantaginaceae). Food Chem. Toxicol. 2018, 111, 44–52. [Google Scholar] [CrossRef]
- Ortan, A.; Fierascu, I.; Ungureanu, C.; Fierascu, R.C.; Avramescu, S.M.; Dumitrescu, O.; Dinu-Pirvu, C.E. Innovative phytosynthesized silver nanoarchitectures with enhanced antifungal and antioxidant properties. Appl. Surf. Sci. 2015, 358, 540–548. [Google Scholar] [CrossRef]
- Fierascu, I.C.; Fierascu, I.; Baroi, A.M.; Ungureanu, C.; Ortan, A.; Avramescu, S.M.; Somoghi, R.; Fierascu, R.C.; Dinu-Parvu, C.E. Phytosynthesis of Biological Active Silver Nanoparticles Using Echinacea purpurea L. Extracts. Materials 2022, 15, 7327. [Google Scholar] [CrossRef]
- Lin, P.C.; Lin, S.; Wang, P.C.; Sridhar, R. Techniques for physicochemical characterization of nanomaterials. Biotechnol. Adv. 2014, 32, 711–726. [Google Scholar] [CrossRef]
- Lungulescu, E.-M.; Setnescu, R.; Pătroi, E.A.; Lungu, M.V.; Pătroi, D.; Ion, I.; Fierăscu, R.-C.; Șomoghi, R.; Stan, M.; Nicula, N.-O. High-Efficiency Biocidal Solution Based on Radiochemically Synthesized Cu-Au Alloy Nanoparticles. Nanomaterials 2021, 11, 3388. [Google Scholar] [CrossRef]
- Ungureanu, C.; Fierascu, I.; Fierascu, R.C.; Costea, T.; Avramescu, S.M.; Călinescu, M.F.; Somoghi, R.; Pirvu, C. In Vitro and In Vivo Evaluation of Silver Nanoparticles Phytosynthesized Using Raphanus sativus L. Waste Extracts. Materials 2021, 14, 1845. [Google Scholar] [CrossRef] [PubMed]
- Anderson, A.C.; Jonas, D.; Huber, I.; Karygianni, L.; Wölber, J.; Hellwig, E.; Arweiler, N.; Vach, K.; Wittmer, A.; Al-Ahmad, A. Enterococcus faecalis from Food, Clinical Specimens, and Oral Sites: Prevalence of Virulence Factors in Association with Biofilm Formation. Front. Microbiol. 2016, 6, 1534. [Google Scholar] [CrossRef] [PubMed]
- Agudelo Higuita, N.I.; Huycke, M.M. Enterococcal Disease, Epidemiology, and Implications for Treatment. In Enterococci: From Commensals to Leading Causes of Drug Resistant Infection; Gilmore, M.S., Clewell, D.B., Ike, Y., Shankar, N., Eds.; Massachusetts Eye and Ear Infirmary: Boston, MA, USA, 2014. Available online: https://www.ncbi.nlm.nih.gov/books/NBK190429/ (accessed on 26 January 2023).
- Li, M.; Yang, F.; Lu, Y.; Huang, W. Identification of Enterococcus faecalis in a patient with urinary-tract infection based on metagenomic next-generation sequencing: A case report. BMC Infect. Dis. 2020, 20, 467. [Google Scholar] [CrossRef]
- Lefort, A.; Arthur, M.; Garry, L.; Carbon, C.; Courvalin, P.; Fantin, B. Bactericidal activity of gentamicin against Enterococcus faecalis in vitro and in vivo. Antimicrob. Agents Chemother. 2000, 44, 2077–2080. [Google Scholar] [CrossRef]
- Sullam, P.M.; Täuber, M.G.; Hackbarth, C.J.; Sande, M.A. Antimicrobial activity of gentamicin in experimental enterococcal endocarditis. Antimicrob. Agents Chemother. 1985, 27, 224–226. [Google Scholar] [CrossRef] [PubMed]
- Bürk, C.; Dietrich, R.; Açar, G.; Moravek, M.; Bülte, M.; Märtlbauer, E. Identification and characterization of a new variant of Shiga toxin 1 in Escherichia coli ONT:H19 of bovine origin. J. Clin. Microbiol. 2003, 41, 2106–2112. [Google Scholar] [CrossRef]
- Edwards, B.D.; Somayaji, R.; Greysson-Wong, J.; Izydorczyk, C.; Waddell, B.; Storey, D.G.; Rabin, H.R.; Surette, M.G.; Parkins, M.D. Clinical Outcomes Associated with Escherichia coli Infections in Adults with Cystic Fibrosis: A Cohort Study. Open Forum Infect Dis. 2020, 7, ofz476. [Google Scholar] [CrossRef] [PubMed]
- Ludden, C.; Coll, F.; Gouliouris, T.; Restif, O.; Blane, B.; Blackwell, G.A.; Kumar, N.; Naydenova, P.; Crawley, C. Defining nosocomial transmission of Escherichia coli and antimicrobial resistance genes: A genomic surveillance study. Lancet Microbe 2021, 2, E472–E480. [Google Scholar] [CrossRef] [PubMed]
- Ponce, A.G.; Fritz, R.; Del Valle, C.; Roura, S.I. Antimicrobial activity of essential oils on the native microflora of organic swiss chard. LWT Food Sci. Technol. 2003, 36, 679–684. [Google Scholar] [CrossRef]
- Angeloni, S.; Spinozzi, E.; Maggi, F.; Sagratini, G.; Caprioli, G.; Borsetta, G.; Ak, G.; Sinan, K.I.; Zengin, G.; Arpini, S.; et al. Phytochemical Profile and Biological Activities of Crude and Purified Leonurus cardiaca Extracts. Plants 2021, 10, 195. [Google Scholar] [CrossRef] [PubMed]
- Armatu, A.; Colceru-Mihul, S.; Bubueanu, C.; Draghici, E.; Pirvu, L. Evaluation of antioxidant and free scavenging potential of some Lamiaceae species growing in Romania. Rom. Biotechnol. Lett. 2010, 15, 5274–5280. [Google Scholar]
- Matkowski, A.; Piotrowska, M. Antioxidant and free radical scavenging activities of some medicinal plants from the Lamiaceae. Fitoterapia 2006, 77, 346–353. [Google Scholar] [CrossRef]
- Aryal, S.; Baniya, M.K.; Danekhu, K.; Kunwar, P.; Gurung, R.; Koirala, N. Total Phenolic Content, Flavonoid Content and Antioxidant Potential of Wild Vegetables from Western Nepal. Plants 2019, 8, 96. [Google Scholar] [CrossRef]
- Upadhya, V.; Pai, S.R.; Hegde, H.V. Effect of method and time of extraction on total phenolic content in comparison with antioxidant activities in different parts of Achyranthes aspera. J. King Saud. Univ. Sci. 2015, 27, 204–208. [Google Scholar] [CrossRef]
- Nurcholis, W.; Alfadzrin, R.; Izzati, N.; Arianti, R.; Vinnai, B.Á.; Sabri, F.; Kristóf, E.; Artika, I.M. Effects of Methods and Durations of Extraction on Total Flavonoid and Phenolic Contents and Antioxidant Activity of Java Cardamom (Amomum compactum Soland Ex Maton) Fruit. Plants 2022, 11, 2221. [Google Scholar] [CrossRef]
- Emmanuel, W.; Onyeike, O.; Nwaogwugwu, E.; Dikioye Emmanuel, P.; David, J.; Sampson Joe, O. Phytochemical and Essential Oil Characterization of the Aerial Parts of Leonurus cardiaca (Motherworth). Asian J. Appl. Chem. Res. 2022, 11, 55–72. [Google Scholar] [CrossRef]
- Koshovyi, O.; Raal, A.; Kireyev, I.; Tryshchuk, N.; Ilina, T.; Romanenko, Y.; Kovalenko, S.M.; Bunyatyan, N. Phytochemical and Psychotropic Research of Motherwort (Leonurus cardiaca L.) Modified Dry Extracts. Plants 2021, 10, 230. [Google Scholar] [CrossRef] [PubMed]
- Meškauskaitė, D. Evaluation of Essential Oils, Phenolic Compounds and Antioxidant Activity in Medicinal Plant Leonurus cardiaca L. Master’s Thesis, Lithuanian University of Health Sciences, Kaunas, Lithuania, 2014. Available online: https://publications.lsmuni.lt/object/elaba:2210183/ (accessed on 22 January 2023).
- Ali, M.; Kim, B.; Belfield, K.D.; Norman, D.; Brennan, M.; Ali, G.S. Green synthesis and characterization of silver nanoparticles using Artemisia absinthium aqueous extract—A comprehensive study. Mat. Sci. Eng. C 2016, 58, 359–365. [Google Scholar] [CrossRef] [PubMed]
- Danaei, M.; Dehghankhold, M.; Ataei, S.; Hasanzadeh Davarani, F.; Javanmard, R.; Dokhani, A.; Khorasani, S.; Mozafari, M.R. Impact of Particle Size and Polydispersity Index on the Clinical Applications of Lipidic Nanocarrier Systems. Pharmaceutics 2018, 10, 57. [Google Scholar] [CrossRef] [PubMed]
- Berman, J.J. Data Simplification. In Taming Information with Open Source Tools; Morgan Kaufmann: Cambridge, MA, USA, 2016; pp. 135–187. [Google Scholar]
- Kumar, S.; Sandhir, R.; Ojha, S. Evaluation of antioxidant activity and total phenol in different varieties of Lantana camara leaves. BMC Res. Notes 2014, 7, 560. [Google Scholar] [CrossRef]
- Babbar, N.; Oberoi, H.S.; Uppal, D.S.; Patil, R.T. Total phenolic content and antioxidant capacity of extracts obtained from six important fruit residues. Food Res. Int. 2011, 44, 391–396. [Google Scholar] [CrossRef]
- Rahim, N.A.; Roslan, M.N.F.; Muhamad, M.; Seeni, A. Antioxidant Activity, Total Phenolic and Flavonoid Content and LC–MS Profiling of Leaves Extracts of Alstonia angustiloba. Separations 2022, 9, 234. [Google Scholar] [CrossRef]
- Jafari, S.; Salaritabar, A.; Moradi, A.; Khanavi, M.; Samadi, M. Antioxidant activity and total phenolic content of extracts and fractions of cultivated Leonurus cardiaca L. Planta Med. 2010, 76, P376. [Google Scholar] [CrossRef]
- Tupe, R.S.; Kemse, N.G.; Khaire, A.A. Evaluation of antioxidant potentials and total phenolic contents of selected Indian herbs powder extracts. Int. Food Res. J. 2013, 20, 1053–1063. [Google Scholar]

| Extract Used | Extract Concentration (mg/mL) | NP Encoding |
|---|---|---|
| Classical temperature extract (Lt) | 5.00 | LT5 |
| 2.50 | LT2.5 | |
| 2.00 | LT2 | |
| 1.25 | LT1.25 | |
| 1.00 | LT1 | |
| Microwave-assisted obtained extract (Lmw) | 5.00 | LM5 |
| 2.50 | LM2.5 | |
| 2.00 | LM2 | |
| 1.25 | LM1.25 | |
| 1.00 | LM1 |
| Extract/Parameter | Lt | Lmw |
|---|---|---|
| TPC (μg GAE/g dry extract) | 537.75 ± 15.44 a | 422.13 ± 14.15 b |
| TF (mg RE/g dry extract) | 40.80 ± 0.29 a | 40.91 ± 0.17 a |
| Gallic acid (mg/g) | 0.518 ± 0.026 a | 0.284 ± 0.014 b |
| Chlorogenic acid (mg/g) | 0.202 ± 0.007 a | 0.197 ± 0.007 a |
| Coumaric acid (mg/g) | 0.537 ± 0.02 a | 0.053 ± 0.002 b |
| Caffeic acid (mg/g) | 0.459 ± 0.019 b | 0.515 ± 0.021 a |
| Hyperoside (mg/g) | 0.214 ± 0.009 a | 0.186 ± 0.006 b |
| Rutin (mg/g) | 1.62 ± 0.065 a | 1.02 ± 0.031 b |
| Naringin (mg/g) | 1.78 ± 0.054 b | 2.27 ± 0.091 a |
| Naringenin (mg/g) | 0.273 ± 0.01 b | 0.322 ± 0.011 a |
| Catechin (mg/g) | 6.33 ± 0.312 b | 58.3 ± 2.74 a |
| Delphinidin (mg/g) | 24.5 ± 0.915 a | 24.8 ± 0.88 a |
| Malvidin (mg/g) | N.D. | 1.48 ± 0.061 |
| Epicatechin (mg/g) | N.D. | N.D. |
| Genistein (mg/g) | N.D. | N.D. |
| Time | Lt Samples | Lmw Samples | ||||||||||||||||||
|---|---|---|---|---|---|---|---|---|---|---|---|---|---|---|---|---|---|---|---|---|
| LT5 | LT2.5 | LT2 | LT1.25 | LT1 | LM5 | LM2.5 | LM2 | LM1.25 | LM1 | |||||||||||
| Pmax (nm) | DNP (nm) | Pmax (nm) | DNP (nm) | Pmax (nm) | Pmax (nm) | DNP (nm) | Pmax (nm) | DNP (nm) | Pmax (nm) | Pmax (nm) | DNP (nm) | Pmax (nm) | DNP (nm) | Pmax (nm) | DNP (nm) | Pmax (nm) | DNP (nm) | Pmax (nm) | DNP (nm) | |
| 20 h | - | - | - | - | - | - | 451 | 61 | - | - | - | - | - | - | - | - | 454 | 64 | 473 | 75 |
| 40 h | - | - | - | - | 470 | 73 | 450 | 60 | - | - | - | - | 462 | 69 | - | - | 451 | 61 | - | - |
| 60 h | - | - | - | - | 464 | 69 | - | - | 454 | 64 | - | - | - | - | 451 | 61 | - | - | 471 | 74 |
| 112 h | 437 | 48 | 453 | 62 | - | - | 443 | 54 | - | - | 463 | 69 | 446 | 57 | - | - | 443 | 54 | - | - |
| 132 h | - | - | - | - | 455 | 64 | - | - | 436 | 48 | - | - | - | - | 450 | 60 | - | - | 445 | 56 |
| 136 h | 434 | 47 | 449 | 59 | - | - | 443 | 54 | - | - | 453 | 62 | 445 | 56 | - | - | 439 | 49 | - | - |
| 156 h | - | - | - | - | 451 | 61 | - | - | 435 | 47 | - | - | - | - | 440 | 50 | - | - | 443 | 54 |
| 184 h | 427 | 41 | 441 | 51 | - | - | 442 | 53 | - | - | 446 | 57 | 444 | 55 | - | - | 438 | 49 | - | - |
| 204 h | - | - | - | - | 443 | 54 | - | - | 434 | 47 | - | - | - | - | 436 | 48 | - | - | 438 | 49 |
| 9 months | 431 | 42 | 427 | 41 | 425 | 41 | 433 | 45 | 419 | 31 | 428 | 42 | 428 | 42 | 420 | 32 | 433 | 45 | 418 | 31 |
| Sample | P1 | SP1 | % P1 | P2 | SP2 | % P2 | P3 | SP3 | % P3 | Average | PdI | DLS Observations |
|---|---|---|---|---|---|---|---|---|---|---|---|---|
| LT5 | 103.1 | 49.60 | 71.3 | 468.9 | 160.3 | 19.8 | 17.41 | 3.612 | 6.3 | 123.5 | 0.380 | Bimodal, reproducible |
| LT2.5 | 87.46 | 40.80 | 92.7 | 9.756 | 3.605 | 7.3 | 58.21 | 0.302 | Bimodal, reproducible | |||
| LT2 | 82.68 | 44.77 | 87.2 | 10.11 | 3.314 | 11.2 | 4528 | 863.5 | 1.6 | 46.87 | 0.464 | Bimodal, reproducible, polydisperse, contains large aggregates |
| LT1.25 | 72.26 | 34.57 | 90.7 | 6.757 | 1.873 | 9.3 | - | - | - | 43.87 | 0.443 | Bimodal, reproducible |
| LT1 | 73.90 | 34.95 | 86 | 8.532 | 2.987 | 12 | 4839 | 705.7 | 2 | 43.49 | 0.467 | Bimodal, reproducible, polydisperse, contains large aggregates |
| LM5 | 86.54 | 31.31 | 65.8 | 1273 | 563.1 | 17.9 | 4276 | 976.2 | 8.6 | 87.52 | 0.555 | Bimodal, reproducible, contains large aggregates |
| LM2.5 | 80.22 | 40.70 | 80.5 | 10.21 | 3.444 | 16.9 | 4508 | 876.3 | 2.7 | 39.35 | 0.552 | Bimodal, reproducible, polydisperse, contains large aggregates |
| LM2 | 77.95 | 39.63 | 87.5 | 9.536 | 3.666 | 12.5 | - | - | - | 41.37 | 0.492 | Bimodal, reproducible |
| LM1.25 | 72.05 | 35.55 | 89.6 | 6.531 | 1.929 | 10.4 | - | - | - | 39.86 | 0.487 | Bimodal, reproducible, polydisperse |
| LM1 | 69.65 | 32.69 | 86.5 | 7.178 | 2.031 | 13.5 | - | - | - | 36.28 | 0.486 | Bimodal, reproducible, polydisperse |
| Sample | (111) Peak Position (Degrees) | (220) Peak Position (Degrees) | (311) Peak Position (Degrees) | FWHM (Degrees) 1 | Crystallite Size (nm) 1 |
|---|---|---|---|---|---|
| LT5 | 37.86 | 64.46 | 77.48 | 2.108 | 4.16 |
| LT2.5 | 38.28 | 64.67 | 77.12 | 2.081 | 4.22 |
| LT2 | 38.28 | 64.75 | 77.55 | 2.107 | 4.17 |
| LT1.25 | 38.28 | 64.60 | 77.48 | 3.317 | 2.65 |
| LT1 | 38.21 | 64.59 | 77.19 | 3.387 | 2.59 |
| LM5 | 38.14 | 64.39 | 77.12 | 1.609 | 5.45 |
| LM2.5 | 38.07 | 64.56 | 77.38 | 1.965 | 4.47 |
| LM2 | 38.07 | 64.42 | 77.55 | 2.249 | 3.90 |
| LM1.25 | 38.28 | 65.53 | 76.55 | 2.321 | 3.78 |
| LM1 | 37.99 | 64.75 | 77.62 | 3.673 | 2.39 |
Disclaimer/Publisher’s Note: The statements, opinions and data contained in all publications are solely those of the individual author(s) and contributor(s) and not of MDPI and/or the editor(s). MDPI and/or the editor(s) disclaim responsibility for any injury to people or property resulting from any ideas, methods, instructions or products referred to in the content. |
© 2023 by the authors. Licensee MDPI, Basel, Switzerland. This article is an open access article distributed under the terms and conditions of the Creative Commons Attribution (CC BY) license (https://creativecommons.org/licenses/by/4.0/).
Share and Cite
Fierascu, I.C.; Fierascu, I.; Baroi, A.M.; Ungureanu, C.; Spinu, S.; Avramescu, S.M.; Somoghi, R.; Fierascu, R.C.; Dinu-Parvu, C.E. Phytosynthesis of Silver Nanoparticles Using Leonurus cardiaca L. Extracts. Materials 2023, 16, 3472. https://doi.org/10.3390/ma16093472
Fierascu IC, Fierascu I, Baroi AM, Ungureanu C, Spinu S, Avramescu SM, Somoghi R, Fierascu RC, Dinu-Parvu CE. Phytosynthesis of Silver Nanoparticles Using Leonurus cardiaca L. Extracts. Materials. 2023; 16(9):3472. https://doi.org/10.3390/ma16093472
Chicago/Turabian StyleFierascu, Ioana Catalina, Irina Fierascu, Anda Maria Baroi, Camelia Ungureanu, Simona Spinu, Sorin Marius Avramescu, Raluca Somoghi, Radu Claudiu Fierascu, and Cristina Elena Dinu-Parvu. 2023. "Phytosynthesis of Silver Nanoparticles Using Leonurus cardiaca L. Extracts" Materials 16, no. 9: 3472. https://doi.org/10.3390/ma16093472
APA StyleFierascu, I. C., Fierascu, I., Baroi, A. M., Ungureanu, C., Spinu, S., Avramescu, S. M., Somoghi, R., Fierascu, R. C., & Dinu-Parvu, C. E. (2023). Phytosynthesis of Silver Nanoparticles Using Leonurus cardiaca L. Extracts. Materials, 16(9), 3472. https://doi.org/10.3390/ma16093472

